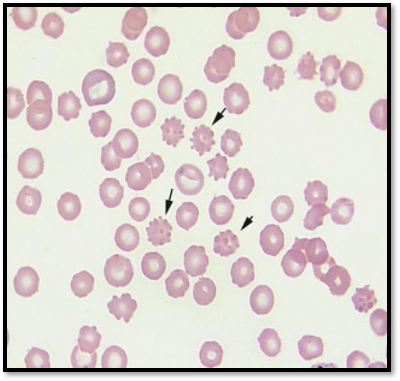
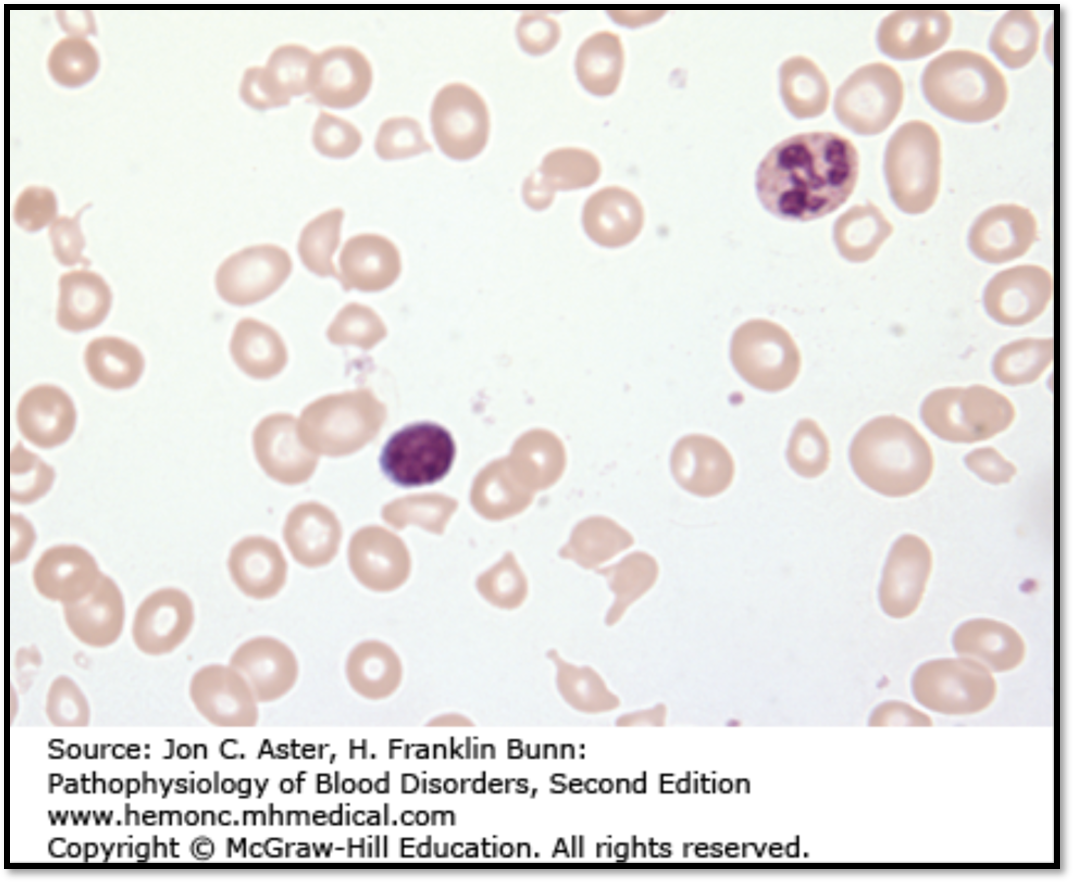

The attached image compares a marrow aspirate from a normal individual with the BM aspirate from an individual with the condition described below:
Vegetarian
Pallor, lemon yellow tinged skin
beefy red tongue
PS: hypersegmented neutrophils
What are the 3 key BM findings in this condition?
Deborah Dalmeida MD

Deborah Dalmeida MD

Deborah Dalmeida MD
Deborah Dalmeida MD
peripheral pancytopenia (decreased RBCs, WBCs, platelets)
reticulocyte index <2
marrow hypoplasia
No splenomegaly
Deborah Dalmeida MD

Aplastic anemia
Deborah Dalmeida MD
What features on a peripheral smear are characteristic of myelophthisic anemia?
Deborah Dalmeida MD
abnormal release of nucleated erythroid precursors and immature granulocytic forms ka leukoerythroblastic reaction
teardrop cells
Deborah Dalmeida MD
two important biochemical reactions requiring Vitamin B12
Deborah Dalmeida MD
Deborah Dalmeida MD
autoimmune disorder characterized by the destruction of gastric parietal cells
Deborah Dalmeida MD
Deborah Dalmeida MD
Time duration before a reticulocyte repsonse is observed in acute blood loss?
Deborah Dalmeida MD
5-7 days
Deborah Dalmeida MD
Differentiate folic acid versus Vit B 12 deificiency
Deborah Dalmeida MD
decreased folate levels in the serum or red cells.
serum homocysteine levels are increased, but methylmalonate concentrations are normal
neurologic changes do not occur.
Deborah Dalmeida MD
List 4 causes for Vitamin B12 deficiency apart from decreased intake.
Deborah Dalmeida MD
a. gastrectomy
b. ileal resection/disease
c. fish tapeworm infestation
d. bacterial overgrowth in blind loops and bowel diverticula
Deborah Dalmeida MD
How does methotrexate cause folic acid deficiency?
Deborah Dalmeida MD
Inhibits dihydrofolate reductase
Deborah Dalmeida MD
most common cause for folic acid deficiency
Deborah Dalmeida MD
alcoholism
Deborah Dalmeida MD
Lab findings in Vit B12 deficiency apart from PS and BM
Deborah Dalmeida MD
low serum vitamin B12 <200pg/ml
elevated serum levels of homocysteine
Elevated methyl malonic acid
MCV >110 fL
Deborah Dalmeida MD
Why do you get a slight increase in the level of nonconjugated bilirubin in the serum and a marked increase in serum lactate dehydrogenase (LDH) in megaloblastic anemia?
Deborah Dalmeida MD
increased rate of apoptosis of erythroid precursor cells due to derangement in DNA synthesis
Deborah Dalmeida MD
Stomach morphology in pernicious anemia
Deborah Dalmeida MD
Fundic gland atrophy
Intestinal metaplasia
Deborah Dalmeida MD
features of megaloblastic anemia on peripheral smear
Deborah Dalmeida MD
macro-ovalocytes
Anisocytosis
Poikilocytosis
Neutrophils are larger than normal and show nuclear hypersegmentation, having five or more nuclear lobules instead of the normal three to four
reticulocyte count is low
Deborah Dalmeida MD
Deborah Dalmeida MD
Deborah Dalmeida MD
Name the type of anemia described below:
space-occupying lesions replace normal marrow elements
Deborah Dalmeida MD
Myelophthisic anemia
Deborah Dalmeida MD
2 possible causes for myelophthisic anemia
Deborah Dalmeida MD
Deborah Dalmeida MD
Deborah Dalmeida MD
lateral corticospinal tract (LCST) - spasticity.
dorsal spinocerebellar tract (DSCT) - ataxia.
Deborah Dalmeida MD
List 3 causes for pure red cell aplasia
Deborah Dalmeida MD
Parvovirus B19 infection
Diamond-Blackfan syndrome
Thymomas
Deborah Dalmeida MD
Identify this condition
a. normocytic normochromic anemia with reticulocytopenia
b. presents during the first 6 months of life
c. Short stature
Craniofacial – snub nose, wide spaced eyes
Thumb abnormalities – triphalangeal etc
Deborah Dalmeida MD
Diamond Blackfan Syndrome
Deborah Dalmeida MD
Which enzyme levels are elevated in Diamond Blackfan Syndrome?
Deborah Dalmeida MD
erythrocyte Adenosine deaminase
Deborah Dalmeida MD